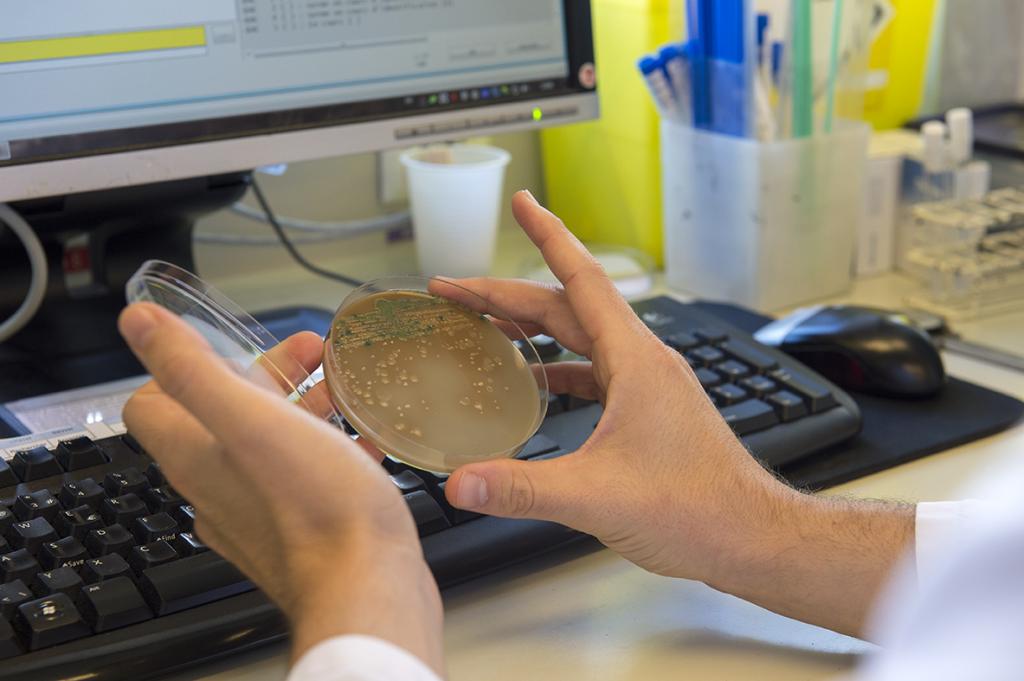
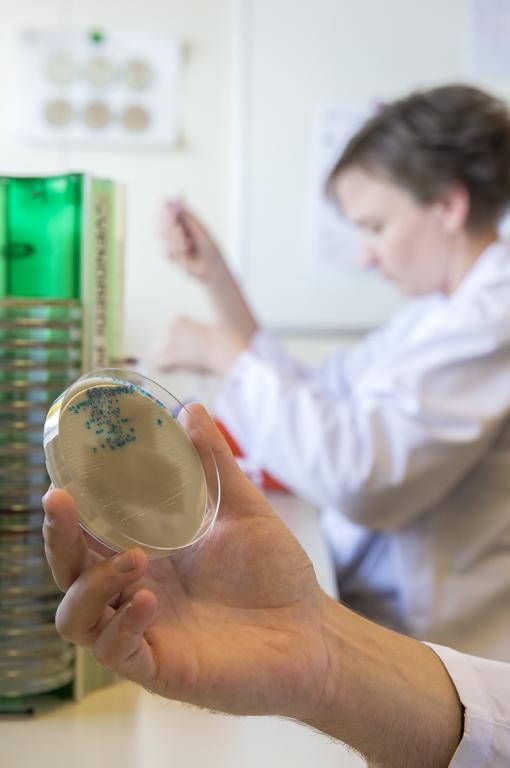
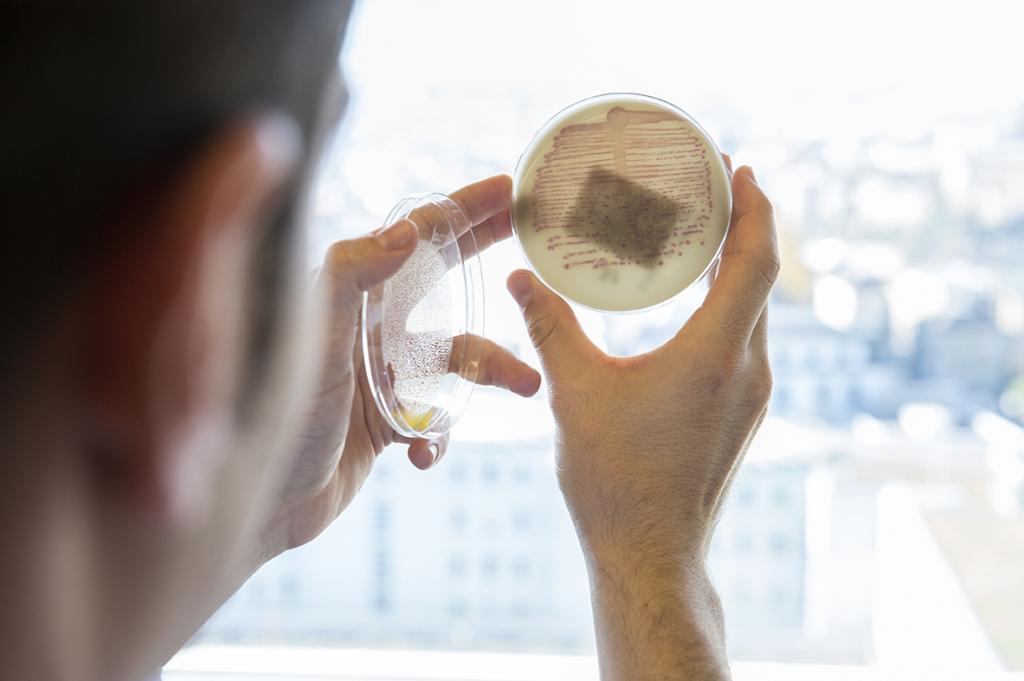

Technicien en analyses biomédicales, Technicienne en analyses biomédicales
CHUV - Service d'Immunologie
CHUV - Laboratoire d'Hématologie